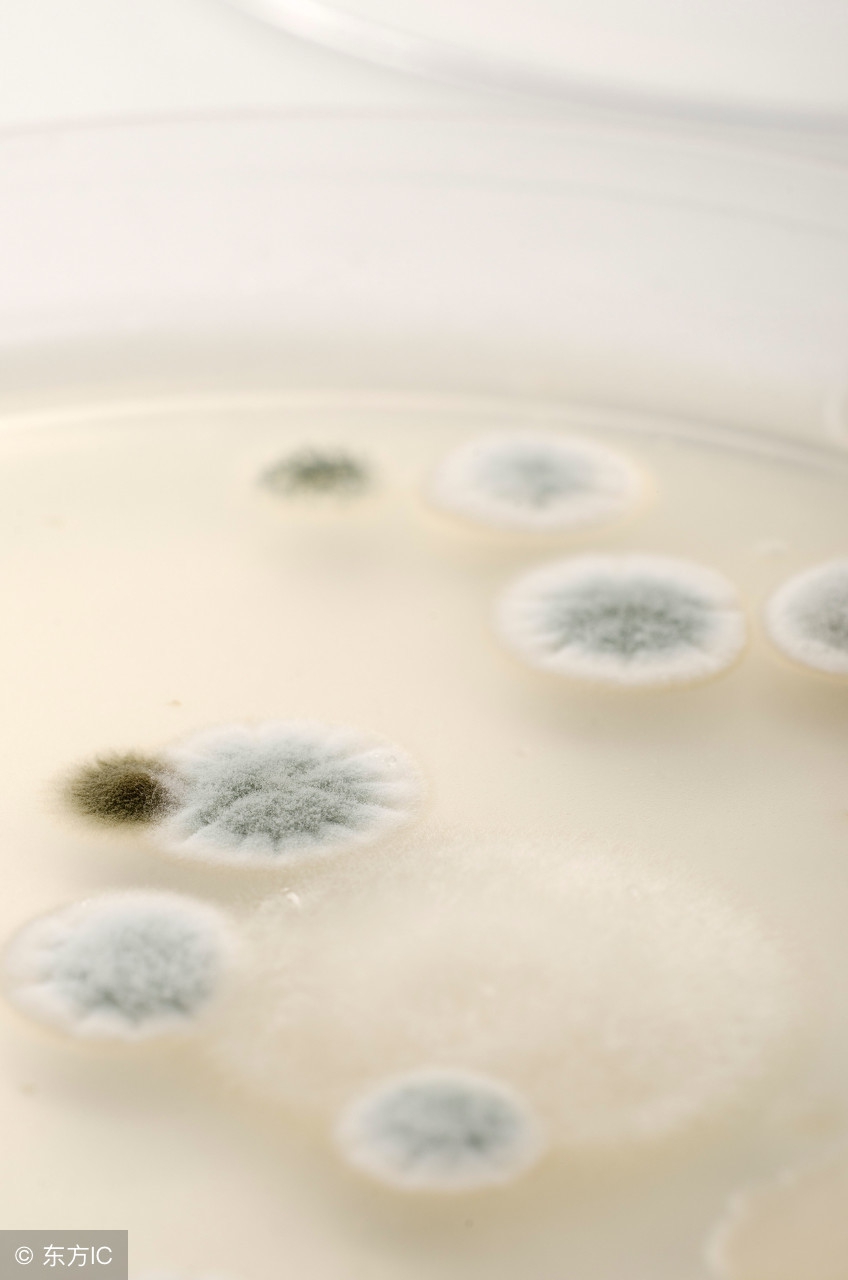
为什么有的猪场给仔猪断尾,仔猪断尾为什么会感染

小小猪尾巴是猪身体中极其重要的器官,有多种生理功能,还可以判断猪只健康,本文主要分析关于猪尾巴在饲养工艺中的作用。

尾巴对猪有多种生理功能,首先尾巴可以驱赶蚊蝇等飞虫,免除飞虫对后躯尤其是会阴部脆弱部位的骚扰。其次,在跑动、跳跃时对猪有轻度的平衡作用。其实猪尾巴最常用的功能是传递感情:在生活开心时尾巴是左摇右晃、悠然自得;吃得开心时,尾巴摇得又快又猛,几乎成360度圆周运动;在害怕、有伤痛、寒冷时会把尾巴夹在后腿之间,时有颤抖表现;而在极度兴奋时,如打斗、争食、配种时其尾则有强直性上举动作。
猪尾巴对1-28日龄仔猪的饲养工艺有不可取代的重要用途:饲养员需要将仔猪捉出产床(或产栏、圈)进行打耳号(或耳刺等标记)、阉割、补铁注射等操作,只要趁仔猪睡觉时提其尾将其倒置提出,仔猪尾椎柔韧性极好,尾部触觉神经不敏感,技术好的工人将仔猪提出到猪栏之外仔猪依然处于熟睡状态。操作完了再提其尾送回母猪身边,以减小应激。这个操作很重要,如果是抓仔猪后腿、腰背、耳朵等处,仔猪立即惊醒大叫,引起母猪受惊,全窝仔猪一起受惊,必然使母猪的产乳机能和仔猪的正常生长发育大打折扣。

我们华人的祖先养了五千年猪了,从来没有剪尾一说,那是因为“小猪捉尾,大猪捉腿”的习惯已传承千年。与此同时,仔猪营养和健康状况全写在小尾巴上了,一看小猪尾巴皮红毛亮(黑毛者看猪皮,粉嫩剔透),走动时小尾巴时时轻摇、动作轻盈利索,这是营养良好、身体健康的表现。如果尾巴下垂、摆动无力,表皮粗糙、皲裂甚至结痂,尾毛焦黄,这是营养不良的预兆(此时腰背部的皮肤症状尚未表现出来)。有经验的养猪人会从仔猪尾巴的表现得到诸多重要信息,以便对饲养方法及时进行调整。
剪掉尾巴 真的解决问题吗?自从西方发达国家开始集约化养猪以来,由于高密度监狱式养猪,仔猪在应激无奈之下普遍发生咬尾恶癖。可悲的是西方所谓的工厂化养猪对咬尾只会治标不治本。他们居然发明了剪尾钳,把剪尾工艺作为指定的工艺流程。尾巴剪掉以后,没有猪尾巴产品了,西方人也不在乎,反正人家不吃这些下料。可是,剪掉尾巴以后问题丝毫没有解决,尾部形成溃疡者居多。此外,有恶癖的仔猪开始发起第2轮进攻,开始咬耳、咬头,怎么办?把耳朵和头也剪掉?经过20~30年束手无策,西方的集约化养猪者才悟出这种掩耳盗铃和刻舟求剑的致残工艺是何等的愚昧。

看看现代西欧的集约化养猪在废除了限位栏的同时也废除了剪尾。我们中华民族的养猪有着举世无双的历史经验。适合中国的养猪技术我们在吸收欧美现代养猪技术的同时也要掂量掂量这些洋玩意,哪些适用于中国,哪些不适用于中国,哪些根本就不如中国的传统技术。对剪尾洋工艺能看透的叫做醒悟,能辨证分析治理咬尾的叫做觉悟,只会跟着洋教条继续剪尾的叫做执迷不悟。
因为仔猪咬尾是仔猪用它的肢体语言告诉我们:猪场里必有猪舍结构、清洁卫生、饲料营养、霉菌毒素、体内外寄生虫、猪群密度和组群模式、温度光线、风速湿度、缺乏玩具等问题,可能是上述问题之一,也可能是几个问题的组合。
错误的就要纠正这是在催促我们去发现和检讨我们工作中的失误。当我们把工作中的错误纠正,短板加长,程序捋顺时,仔猪自然而然不会去咬尾了。何必剪尾?留下这条肉体信息指挥棒是明智之举。